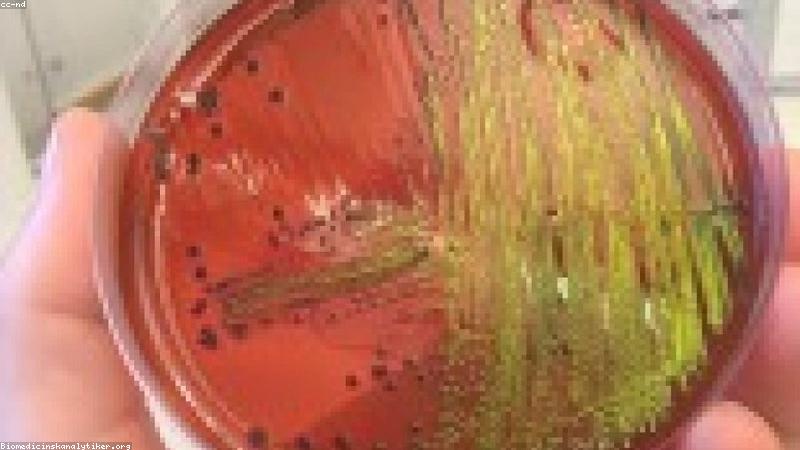
Cơ chế tiêu diệt vi khuẩn của tia UV

Phân tích chi tiết: Có nên đầu tư máy tiệt trùng bình sữa UV không?
Trong hành trình chăm sóc trẻ sơ sinh, việc đảm bảo vệ sinh cho các dụng cụ ăn uống của bé là ưu tiên hàng đầu. Những năm gần đây, thị trường thiết bị mẹ và bé đã chứng kiến sự chuyển dịch mạnh mẽ từ các phương pháp tiệt trùng truyền thống bằng hơi nước sang công nghệ tia cực tím (UV). Tuy nhiên, với mức giá thường cao hơn gấp 2-3 lần so với máy hơi nước, nhiều phụ huynh vẫn băn khoăn: "Liệu máy tiệt trùng UV có thực sự xứng đáng với số tiền bỏ ra?"
Tại BabyGear Hub, chúng tôi hiểu rằng mỗi quyết định mua sắm đều cần dựa trên sự phân tích khoa học và tính ứng dụng thực tế. Bài viết này sẽ phân tích chi tiết mọi khía cạnh của công nghệ UV để giúp bạn đưa ra lựa chọn đúng đắn nhất.

1. Công nghệ tiệt trùng UV là gì và hoạt động như thế nào?
Khác với phương pháp sử dụng nhiệt độ cao từ hơi nước để tiêu diệt vi khuẩn, máy tiệt trùng UV sử dụng tia cực tím (thường là dải sóng UV-C có bước sóng từ 200 đến 280nm). Đây là dải sóng có năng lượng cao nhất, có khả năng xuyên thấu qua màng tế bào của vi khuẩn, virus và các loại nấm mốc.
Cơ chế tác động sinh học
Khi tia UV-C chiếu vào vi sinh vật, nó sẽ phá hủy cấu trúc DNA và RNA của chúng. Quá trình này ngăn chặn khả năng tái bản và làm bất hoạt các chức năng sống cơ bản của vi khuẩn. Kết quả là các tác nhân gây bệnh bị tiêu diệt hoàn toàn mà không cần đến hóa chất hay nhiệt độ cực cao.
Các loại bóng đèn UV phổ biến
Hiện nay trên thị trường có hai dòng chính:
- Bóng đèn huỳnh quang UV (Mercury Lamp): Hiệu suất cao nhưng cần thay thế định kỳ sau khoảng 6.000 - 8.000 giờ sử dụng.
- Đèn LED UV (UVC LED): Công nghệ mới nhất với độ bền cực cao, không chứa thủy ngân và kích thước nhỏ gọn, giúp tối ưu diện tích khoang chứa.
2. Ưu điểm vượt trội của máy tiệt trùng UV
Tại sao máy UV lại trở thành "ngôi sao" trong các căn bếp hiện đại của các mẹ bỉm sữa? Dưới đây là những lý do cốt lõi:
Tiệt trùng khô hoàn toàn
Sai lầm phổ biến của máy hơi nước là để lại độ ẩm sau khi tiệt trùng. Môi trường ẩm ướt chính là "thiên đường" để vi khuẩn tái xâm nhập. Máy UV thường tích hợp hệ thống sấy khô bằng khí nóng (PTC), đảm bảo bình sữa khô ráo hoàn toàn và sẵn sàng sử dụng ngay lập tức.
Khả năng tiệt trùng đa năng
Đây là ưu điểm lớn nhất so với máy hơi nước. Vì không sử dụng nhiệt độ quá cao và nước, bạn có thể tiệt trùng gần như mọi thứ:
- Điện thoại, iPad, điều khiển từ xa.
- Đồ chơi bằng nhựa, thú nhồi bông nhỏ.
- Phụ kiện máy hút sữa (vốn dễ bị biến dạng do nhiệt).
- Các vật dụng cá nhân như bàn chải đánh răng, bấm móng tay.
Chế độ bảo quản vô trùng lâu dài
Hầu hết các dòng máy UV cao cấp như tại BabyGear Hub đều có chức năng "Storage". Sau chu trình tiệt trùng, máy sẽ tự động kích hoạt tia UV sau mỗi vài giờ để duy trì môi trường vô trùng lên đến 24-72 giờ. Bạn không còn phải lo lắng về việc bình sữa bị nhiễm khuẩn khi để qua đêm.

3. Những hạn chế và lưu ý cần cân nhắc
Mặc dù sở hữu nhiều ưu điểm, máy UV không phải là thiết bị hoàn hảo cho tất cả mọi người. Có 3 vấn đề bạn cần lưu ý:
Hiện tượng "lão hóa" vật liệu
Tia UV theo thời gian có thể làm nhựa (đặc biệt là nhựa không chứa BPA như PP) bị ngả vàng nhẹ hoặc trở nên giòn hơn. Tuy nhiên, với các loại bình sữa cao cấp bằng thủy tinh hoặc nhựa PPSU, tác động này là không đáng kể trong vòng đời sử dụng bình sữa của bé.
Điểm mù của tia sáng
Tia UV chỉ diệt khuẩn được những nơi ánh sáng chiếu trực tiếp vào. Nếu bạn xếp chồng đồ vật lên nhau, những vùng bị che khuất sẽ không được tiệt trùng hiệu quả. Để khắc phục, các máy hiện đại thường được trang bị mặt trong bằng thép không gỉ tráng gương để phản xạ tia sáng đa chiều.
Chi phí đầu tư ban đầu
Một chiếc máy UV chất lượng thường có giá từ 2 triệu đến hơn 5 triệu đồng. Đây là một khoản đầu tư đáng kể so với mức giá vài trăm ngàn của các bộ tiệt trùng lò vi sóng hoặc máy hơi nước đơn giản.
4. So sánh trực diện: UV vs. Hơi nước (Steam)
| Tiêu chí | Máy Tiệt trùng UV | Máy Hơi nước |
|---|---|---|
| Thời gian | 30 - 60 phút (bao gồm sấy) | 8 - 15 phút |
| Độ khô ráo | Khô hoàn toàn | Thường bị đọng nước |
| Vật dụng | Đa dạng (đồ điện tử, vải, nhựa) | Chỉ đồ chịu được nhiệt cao |
| Bảo trì | Thay bóng đèn (nếu cần), lau gương | Vệ sinh cặn canxi đáy máy thường xuyên |
5. Kết luận: Ai nên đầu tư máy tiệt trùng UV?
Sau khi phân tích sâu, BabyGear Hub nhận thấy máy tiệt trùng UV là một khoản đầu tư "đắt xắt ra miếng" nếu bạn thuộc các nhóm sau:
- Cha mẹ bận rộn: Những người cần sự tiện lợi tuyệt đối, chỉ muốn rửa bình, bỏ vào máy và bấm nút là xong.
- Người chú trọng sự an toàn tuyệt đối: Chế độ bảo quản vô trùng giúp bạn luôn có sẵn bình sữa sạch bất kể ngày hay đêm.
- Gia đình muốn sử dụng lâu dài: Khi bé lớn, máy vẫn có ích để tiệt trùng đồ chơi, bàn chải và các thiết bị cá nhân cho cả gia đình.
Ngược lại, nếu ngân sách của bạn hạn hẹp và bạn không ngại việc phải đứng canh để lấy bình sữa ra úp khô sau khi tiệt trùng hơi nước, một chiếc máy hơi nước tích hợp sấy khô cơ bản vẫn có thể hoàn thành tốt nhiệm vụ.

Lời khuyên từ BabyGear Hub: Khi chọn mua máy UV, hãy ưu tiên các thương hiệu có chứng nhận kiểm định nồng độ tia UV và hiệu quả diệt khuẩn từ các tổ chức uy tín như SGS hay Intertek. Đừng quên kiểm tra chế độ bảo hành bóng đèn - bộ phận quan trọng nhất của máy.
Hy vọng bài phân tích này đã giúp bạn gỡ rối được thắc mắc về việc có nên đầu tư máy tiệt trùng UV hay không. Nếu cần tư vấn thêm về các dòng máy cụ thể, đừng ngần ngại liên hệ với đội ngũ chuyên gia của chúng tôi!
